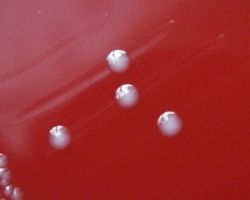
Энтерококк фекальный – нужно ли беспокоиться?

Лекарство «Дазолик». Инструкция по применению
Лекарство «Дазолик» (таблетки) относится к группе противопротозойных средств. Действие медикамента обуславливается нарушением ДНК-структуры в чувствительных микроорганизмах.
Татьяна Рудакова
Лекарство «Дазолик» (таблетки) относится к группе противопротозойных средств. Действие медикамента обуславливается нарушением ДНК-структуры в чувствительных микроорганизмах.
Татьяна Рудакова
Процесс превращения еды в энергию запускается ферментами, выделяемыми органами эндокринной системы. В состав последней входит поджелудочная железа, лечение которой сопряжено с трудностями в диагностике.
Татьяна Рудакова
Медикамент «Тералиджен» относится к нейролептическим препаратам (антипсихотическим средствам). Лекарство обладает умеренной антигистаминной, спазмолитической, серотонинблокирующей, альфа-адреноблокирующей активностью.
Татьяна Рудакова
По сей день ведутся споры по поводу пользы и вреда такого препарата, как борная кислота. Применение его в различных сферах медицины и фармакологии достаточно обширно. Тем не менее данное вещество относится к разряду ядовитых, а значит неправильное использование может привести к серьезным последствиям негативного характера.
Татьяна Рудакова
Энтерококк фекальный относится к условно-патогенной микрофлоре. Патогенная форма указанных микроорганизмов вызывает воспалительные процессы в мочеполовой системе: циститы, пиелонефриты, простатиты, аднекситы, уретриты и т. д.
Татьяна Рудакова
Лекарство «Контрактубекс» относится к категории медикаментов, проявляющих противовоспалительное, антипролиферативное влияние на ткани рубцов.
Татьяна Рудакова
Мало кто знает, что натуральный янтарь содержит в себе очень полезное вещество – одноименную кислоту. Польза янтарной кислоты доказана многими специалистами - докторами медицинских наук.
Татьяна Рудакова
Лекарство эффективно при метеоризме (вздутии в животе, обусловленном повышенным скоплением свободного газа).
Татьяна Рудакова
Препарат «Левомицетин» относится к группе антибиотиков. Механизм его действия определяется активностью хлорамфеникола. Медикамент способствует нарушению белкового синтеза в бактериальной клетке, угнетению размножения и деления микробов.
Татьяна Рудакова
«Овестин» (свечи) - это эстрогенный лекарственный препарат, главным действующим компонентом которого является эстриол. Это вещество является аналогом естественного женского гормона эстрогена и помогает восстановить его уровень в организме женщины в период постменопаузы. Также данный медикамент оказывает положительное действие при заживлении эпителия слизистой оболочки мочеполовых путей, стимулирует восстановление естественной микрофлоры влагалища.
Татьяна Рудакова